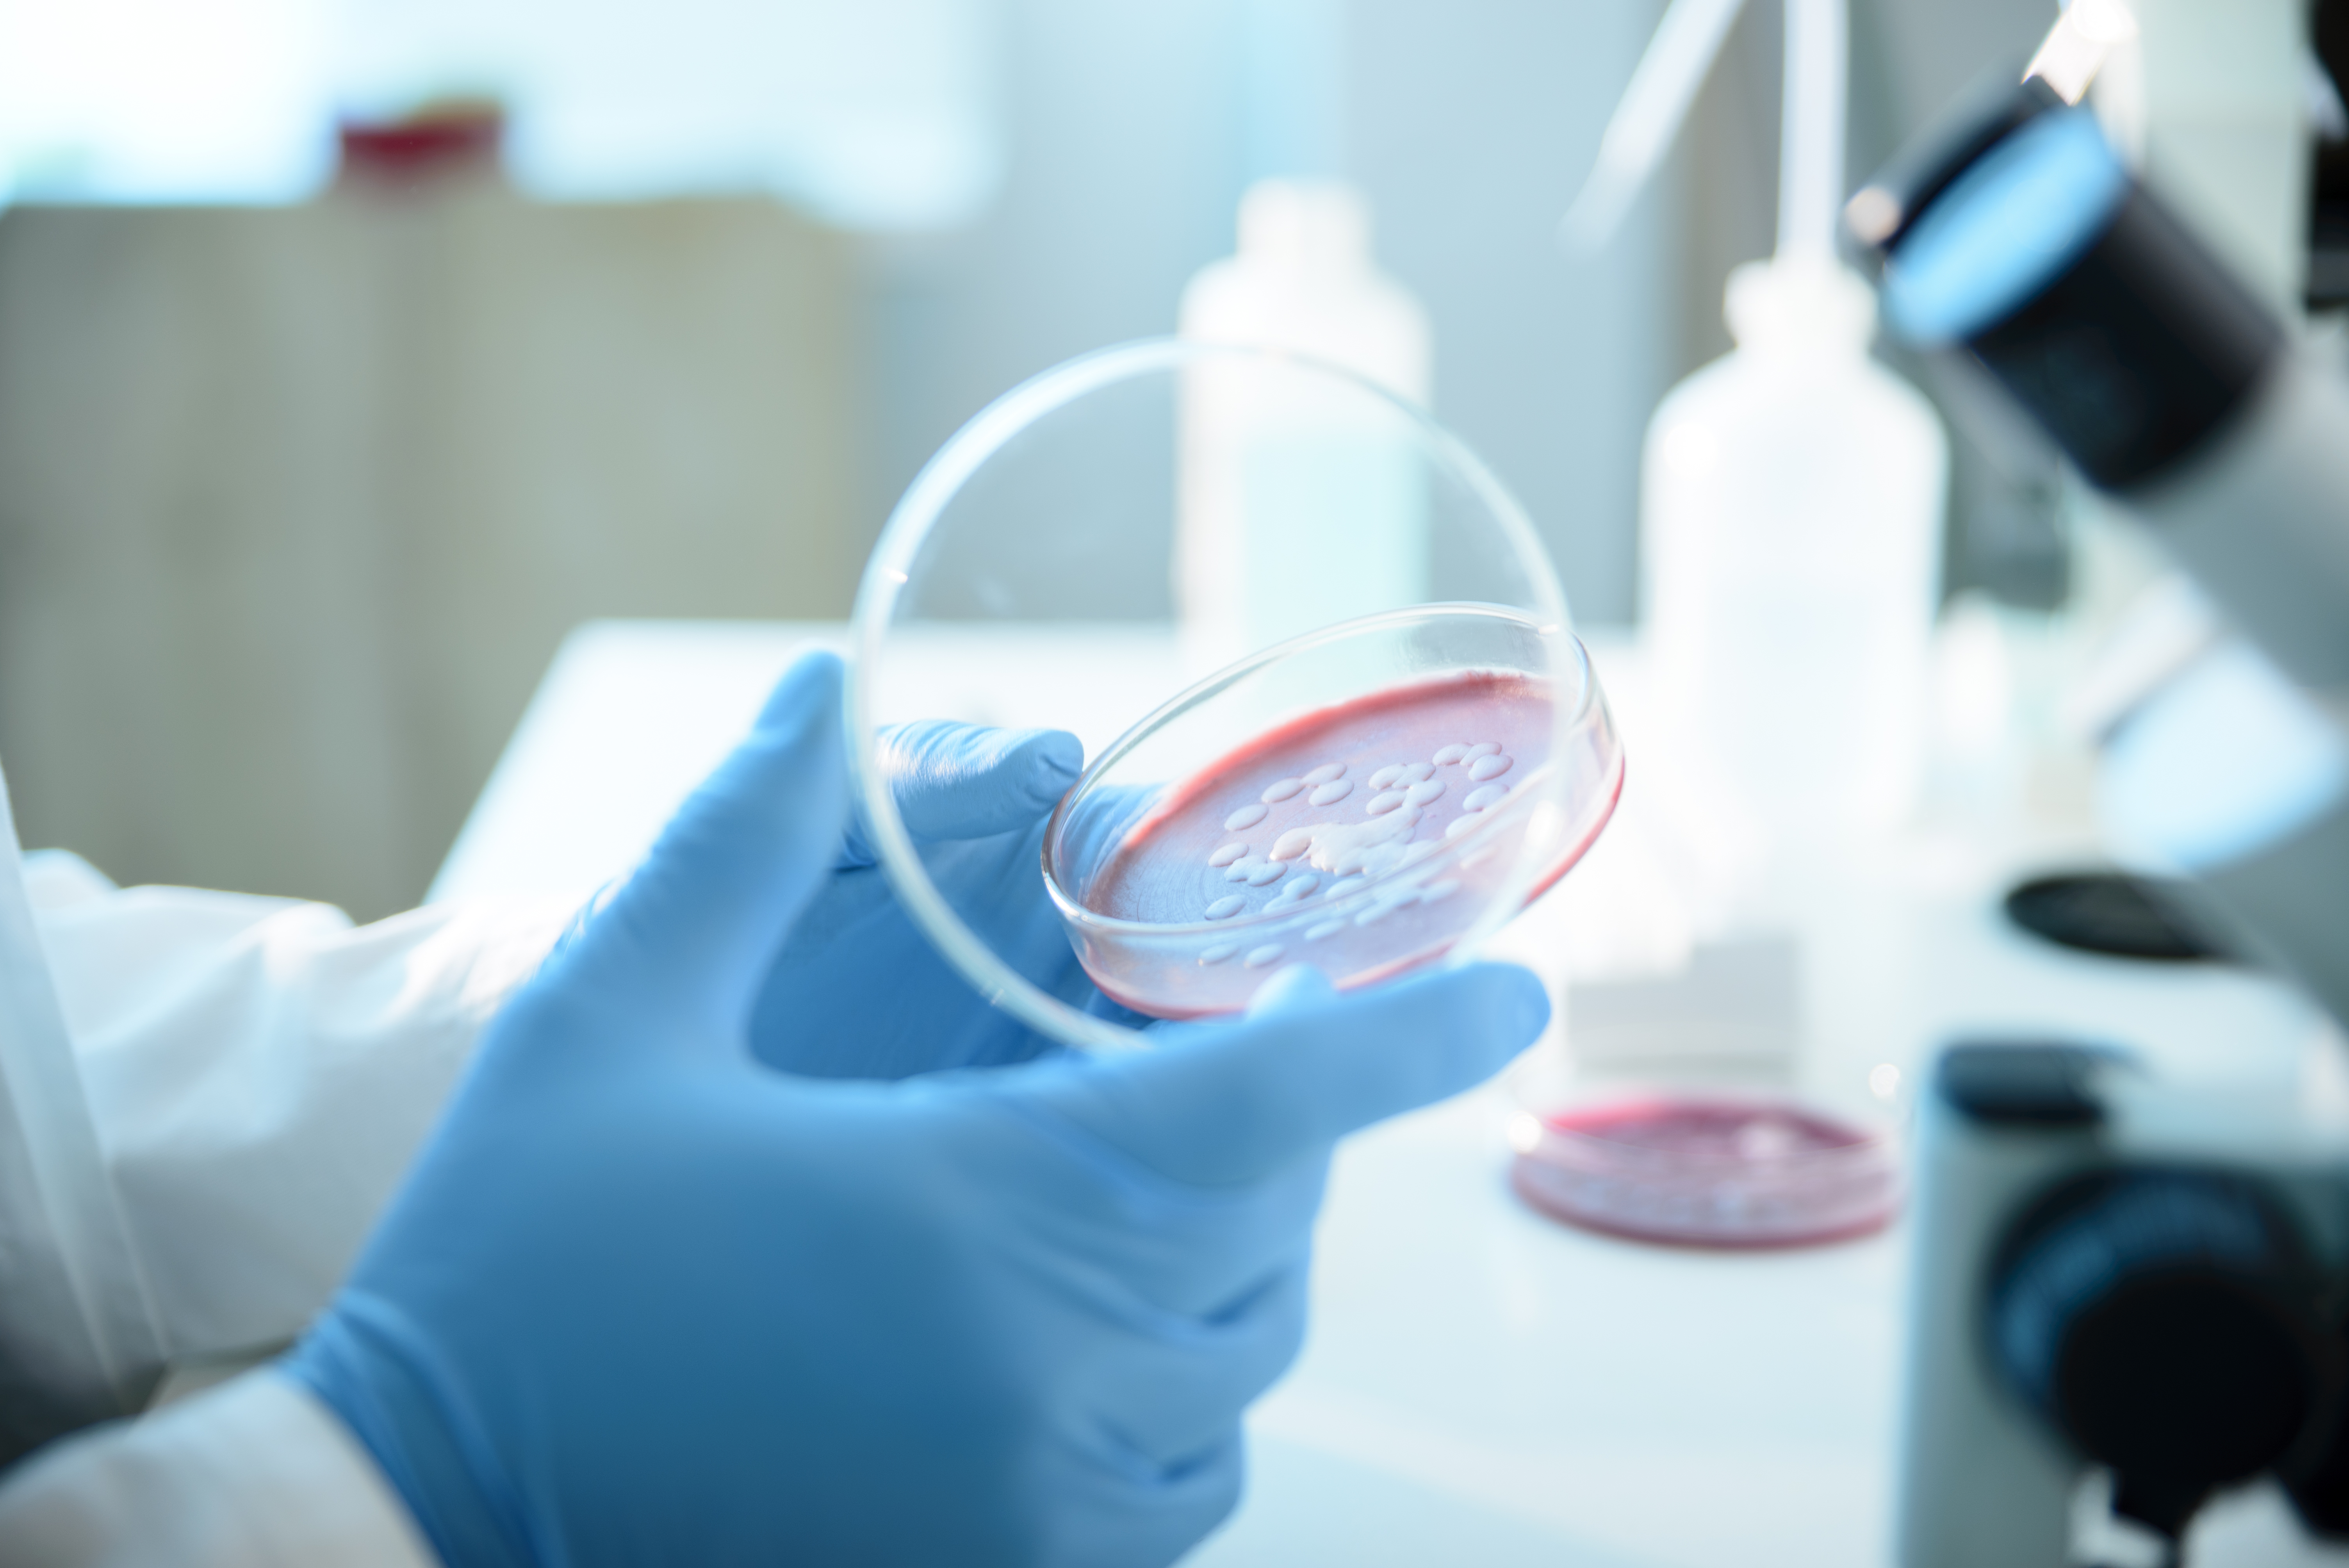
Ce este Serratia marcescens, bacteria descoperită la Spitalul „Sfânta Maria” din Iași, unde au murit șase copii

International
Romaniatv.net
StiriPeSurse.ro
RomaniaLibera.ro
StiriPeSurse.ro
Jurnalul.ro
Romaniatv.net
Romaniatv.net
RomaniaLibera.ro
StiriPeSurse.ro

English (US) ·
Romanian (RO) ·